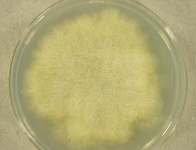

Search Details
| UAMH Number: | 10190 |
|---|---|
| Species Name: | Mucor hiemalis |
| Type: | |
| Synonyms: | Mucor adventitius / Mucor adventitius var. aurantiacus / Mucor corticola / Mucor corticolus / Mucor hiemalis var. albus / Mucor hiemalis var. flavus / Mucor hiemalis var. griseus / Mucor hiemalis var. toundrae / Mucor humicola / Mucor humicolus / Mucor lausannensis / Mucor vallesiacus |
| Taxonomy: | FUNGI Mucoromycota, Mucoromycetes, Mucorales, Mucoraceae |
| Strain History: | M.N. Thormann -> Currah, R.S. (MNT 49) -> UAMH |
| Substrate: | living moss (Sphagnum fuscum) in bog with black spruce (Pices mariana), Labrador tea (Rhododendron groenlandicum) and moss (Sphagnum fuscum) | Location: | CANADA Alberta, Perryvale, 54° 28'N, 113° 16'W (GEO: 54.498,-113.384) |
| Isolator: | M.N. Thormann |
| Isolation Date: | 1998-05-08 |
| Date Received: | 2002-05-27 |
| Characters: | BIODETERIOGEN/ BIODEGRADATION enzymatic abilities - Thormann, Currah & Bayley, The Bryologist 104:548-559, 2001 // BIODETERIOGEN/ BIODEGRADATION in vitro decomposition, degrades cellulose, utilizes starch - Thormann, Currah & Bayley, Can. J. Microbiol. 48:204-211, 2002 // MESOPHILIC grows better @ 25C than at 18C or 30C - // MOLECULAR SYSTEMATICS Blast match ITS 100% similarity to Mucor hiemalis AY243949 CBS 242.35 - fide UAMH 2011 (Click for publications citing UAMH 10190) |
| Compounds: | |
| Cross Reference: | ALTA 10697 |
| Collections: | Living Strains; Dried Herbarium Material |
| Pathogenic Potential: | Human: no | Animal: no | Plant: no |
| Biosafety Risk Group: | RG1 (check the PHAC ePATHogen Risk Group Database for updates) |
| Regulatory Requirements: | No restrictions for Canadian requesters. International requesters must provide all legally required importation documentation prior to shipment. Plant pathogenicity status may be verified by using the USDA Agricultural Research Service (ARS) Fungal Database |
| MycoBank ID: | 249401 |
| Sequences: | >UAMH10190_UAMH_ITS CGATTGAATGGTTATAGTGAGCATATGGGATCAGTAGGATTAAACTGGCAACAGTTTTTCCCTGCAGAGAACTATGGCAAACTAGGCTATTTAGAGGAAGTAAAAGTCGTAACAAGGTTTCCGTAGGTGAACCTGCGGAAGGATCATTAAATAATTTAGATGGCCTTTGCTAGTTTTCTAGCGAATGGTTCATTCTTTTTTACTGTGAACTGTTTTAATTTTTCAGCGTCTGAGGAATGTCTTTTAGCCATAGGGATAGGCTACTAGAATGTTAACCGAGCTGAAAGTCAGGCTTAGGCCTGGTATCCTATTAATTATTTACCAAAAGAATTCAGTATTATAATTGTAACATAAGCGTAAAAAACTTATAAAACAACTTTTAACAACGGATCTCTTGGTTCTCGCATCGATGAAGAACGTAGCAAAGTGCGATAACTAGTGTGAATTGCATATTCAGTGAATCATCGAGTCTTTGAACGCAACTTGCGCTCAATGGTATTCCATTGAGCACGCCTGTTTCAGTATCAAAAACACCCCACATTCATAATTTTGTTGTGAATGGAAATGAGAGTTTCGGCTTTATTGCTGAATTCTTTAAAATTATTAGGCCTGAACTATTGTTCTTTCTGCCTGAACATTTTTTTAATATAAAGGAATGCTCTAGTAAAAAGACTATCTCTGGGGCCTCCCAAATAAATCATTCTTAAATTTGATCTGAAATCAGGCGGGATTACCCG |
IMAGES: